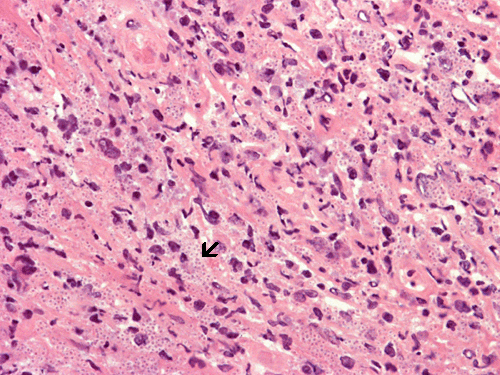

Histoplasmosis, HE stain: Note the numerous small gray dots (arrow). Histoplasma is one of the very few fungal organisms that can be easily visualized on slide without special stains.
Histoplasmosis, PAS stain: Note the numerous small gray dots on the HE stain are strongly positive for PAS.